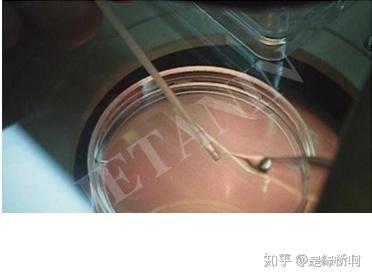

發(fā)布時(shí)間:2025-12-10 16:42:29 作者:試管專家

胚胎冷凍技術(shù)在試管嬰兒治療中是試管十分常見(jiàn)的技術(shù)。試管嬰兒過(guò)程通常獲得多個(gè)胚胎,嬰兒選擇適合的冷凍理步胚胎進(jìn)行移植后,剩余的胚胎的胚胎冷凍保存以便要二次移植,這就是詳解冷凍胚胎。綠橋海外今天帶大家具體了解下冷凍胚胎的試管原理以及過(guò)程,希望大家對(duì)試管嬰兒有更深入的嬰兒了解。

冷凍胚胎
在試管嬰兒過(guò)程中若得到足夠的冷凍理步胚胎,剩余的胚胎胚胎便可被冷藏於-196度的液態(tài)氮內(nèi)。冷凍了的詳解胚胎可供日後解凍後再植入女方體內(nèi)。這樣,試管女方便不須再重新接受整個(gè)人工受孕的嬰兒療程。
胚胎冷凍的冷凍理步優(yōu)勢(shì)
1、降低由于植入太多胚胎導(dǎo)致的胚胎雙胞胎機(jī)率。
2、減少每次培育試管嬰兒需要摧毀的胚胎數(shù)量。
3、通過(guò)增加在適當(dāng)?shù)募に厮街芷谟锌捎门咛ミM(jìn)行移植的機(jī)會(huì),提高懷孕機(jī)率。/、
4、對(duì)于面臨接受化療風(fēng)險(xiǎn)的女性,可提高她們未來(lái)懷孕的機(jī)率。患者可以在治病之前先將卵子冷凍保存,因?yàn)橹委熆赡墚a(chǎn)生副作用,導(dǎo)致絕經(jīng)或不能生育。
5、提高可能結(jié)婚晚的女性的懷孕機(jī)率。
醫(yī)院采用以下兩種方法進(jìn)行胚胎冷凍:
1. 慢速冷凍用于冷凍第一至第三天(二細(xì)胞-卵裂期)的胚胎,通過(guò)慢速平衡降溫的方式,提高存活率。
2. 玻璃化冷凍是目前頗受歡迎的方法,采用快速降溫的方法,使卵子、胚胎和冷凍保護(hù)劑形成玻璃狀固體。快速降溫可避免凍傷卵子,以及在液體組織形成玻璃狀固體的過(guò)程中沒(méi)有冰晶產(chǎn)生,使囊胚階段的胚胎存活率高于第一種冷凍方式。 
綠橋海外:通過(guò)以上的介紹,大家想必對(duì)冷凍胚胎有了基本的認(rèn)識(shí)。冷凍胚胎也算是備孕家庭的一個(gè)福音,只要運(yùn)用得當(dāng),就可以大大提高夫妻懷孕幾率。有什么關(guān)于試管嬰兒的問(wèn)題,都可以咨詢綠橋海外,希望能給備孕夫婦提供到幫助。